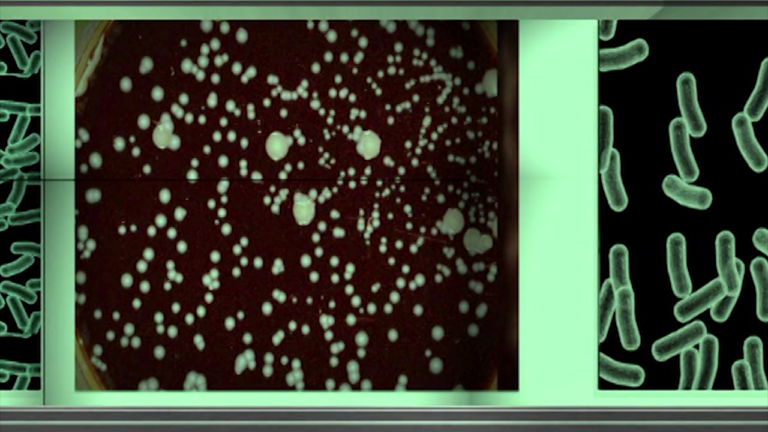

Federal lawsuit filed against Golden Sands alleges inadequate Legionella testing
A Florida couple has filed a $75,000 federal lawsuit claiming that they were exposed to legionnaire's disease while they stayed at the Golden Sands Club Condominium in Ocean City.
Online court records show that Mary Ann and Ronald Budra stayed at the condominium in 2015. In December of that year, Mary Ann reportedly tested positive for the disease.
According to a 2016 CDC report, outbreaks are mostly caused by water in buildings with complex water systems infected with Legionella bacteria. The lawsuit claims that Golden Sands did not have their water system adequately tested for legionella before October 2015. It additionally alleges that when the hotel was tested, the Worcester County Health Department found Legionella in multiple locations.
Golden Sands and the Worcester County Health Department have not yet responded to 47 ABC's requests for statement.